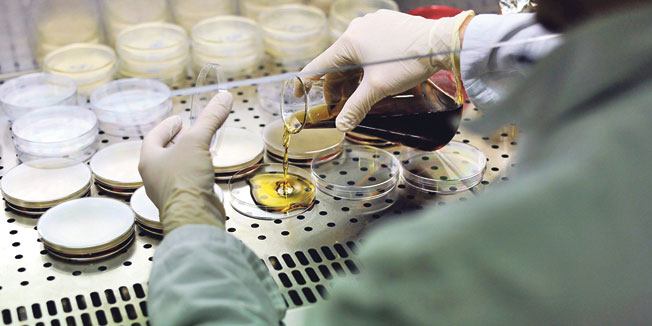
681815.bin

Dvije američke vojne ustanove, pokusni poligon u Dugwayju, u Utahu i kemijsko-biološki centar Edgewood u Marylandu pogreškom su slali sumnjive uzorke živog antraksa od ožujka 2014. do travnja 2015., rekao je u srijedu američki dužnosnik a prenosi agencija Reuters.
Dužnosnik koji je htio ostati neimenovan, rekao je da je vojni poligon u Dugwayju izvijestio, očito pogrješno, kako je gama zračenjem inaktivirao zalihe antraksa.
Uzorci su dobiveni u Dugwayju, a zatim su odatle i iz Edgewooda slani američkim saveznim, privatnim i akademskim ustanovama, rekao je dužnosnik, dodajući da zasad nema opasnosti za stanovništvo.
Pentagon je u srijedu objavio da je sumnjivi uzorak sa živim stanicama antraksa (bedrenice) poslan u američku bazu u Južnoj Koreji, uz uzorke koji su pogreškom po...






Za sudjelovanje u komentarima je potrebna prijava, odnosno registracija ako još nemaš korisnički profil....